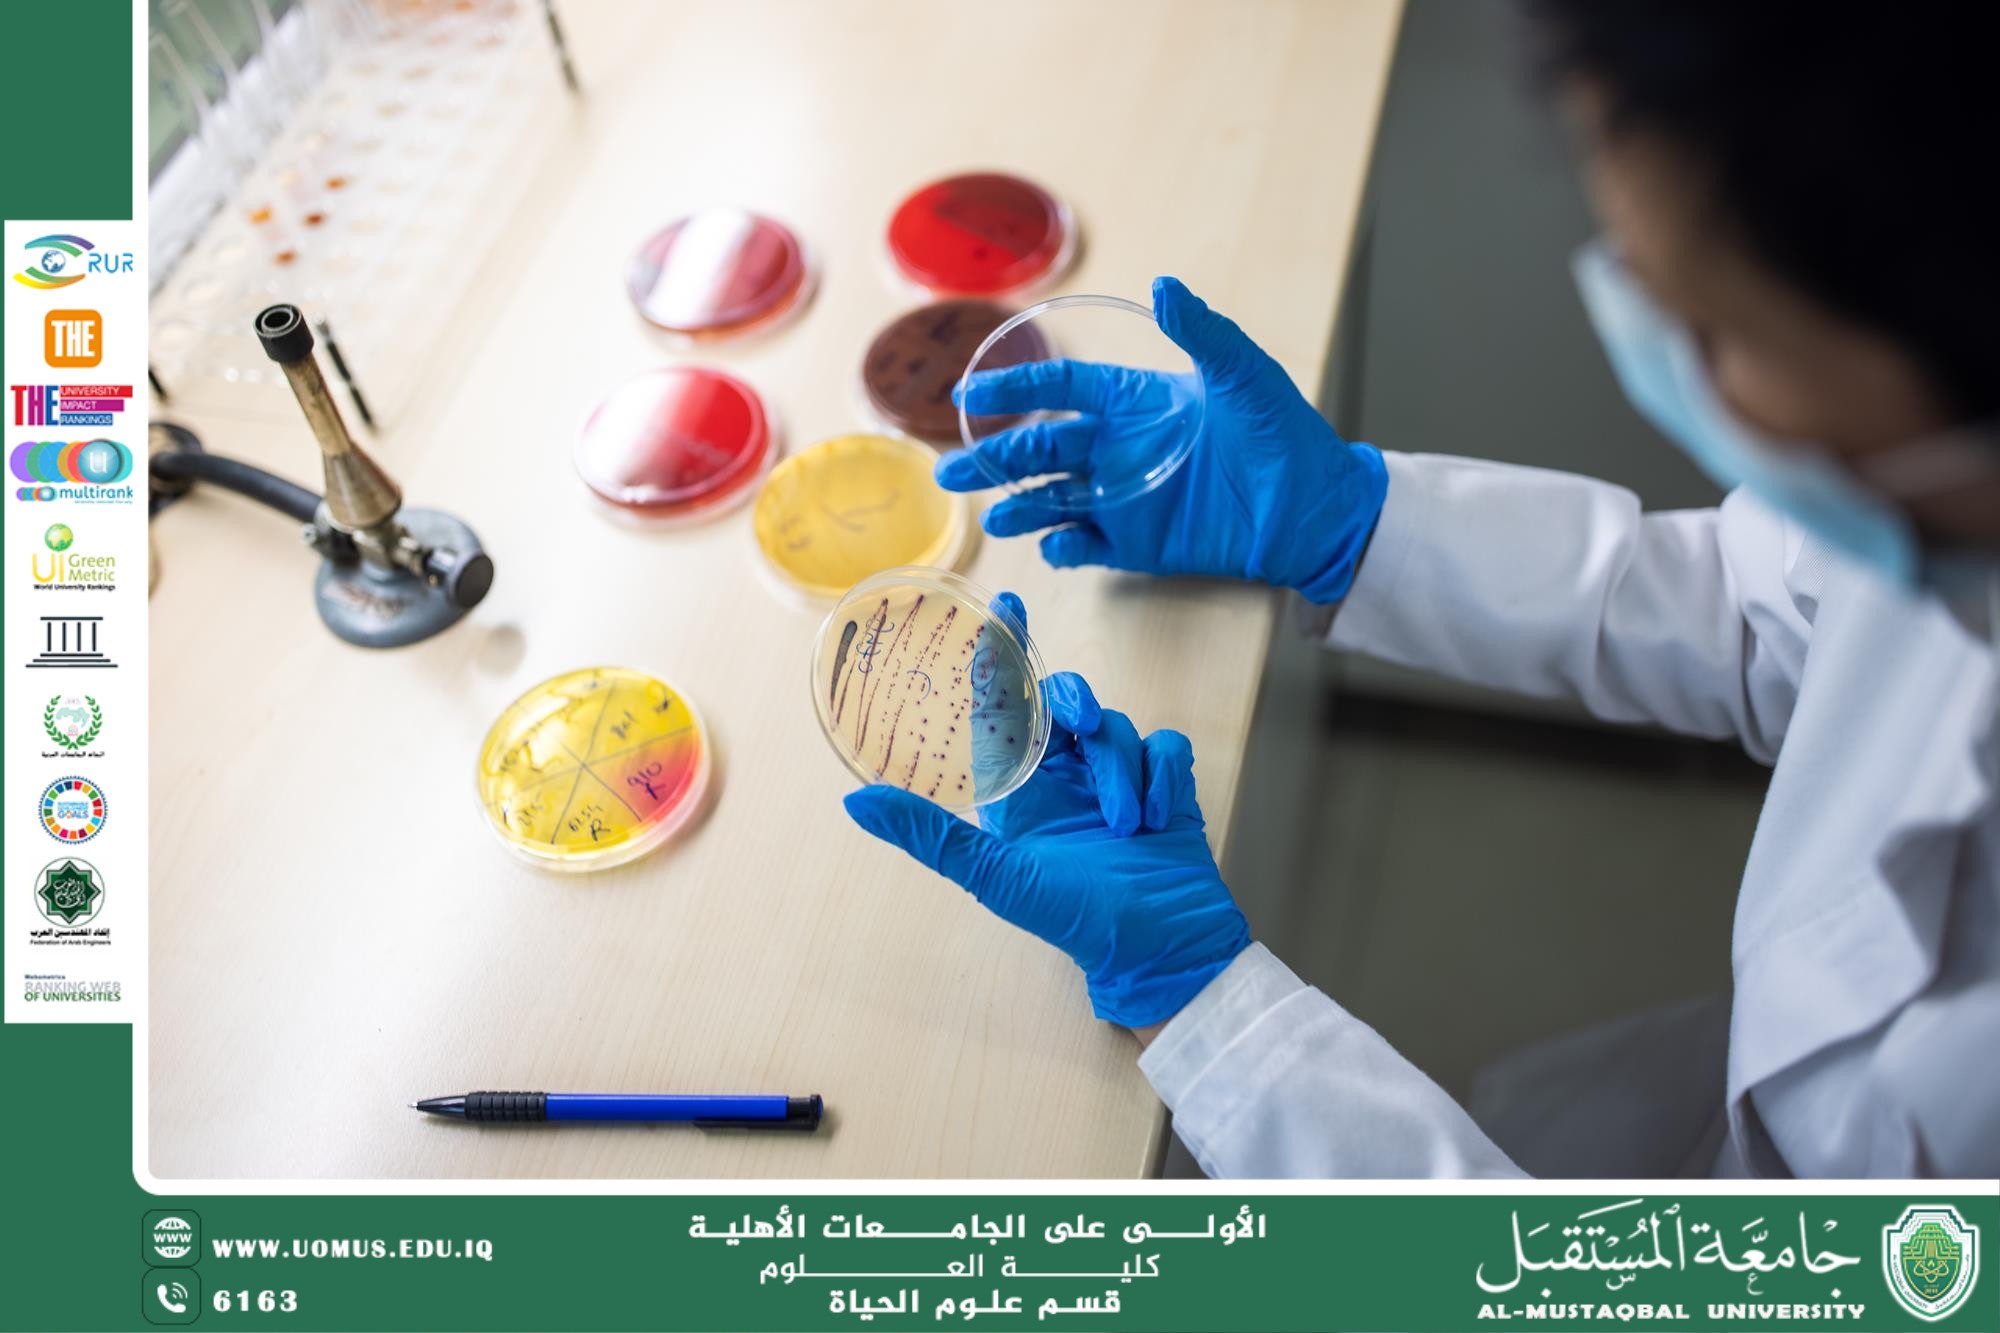
default image

مقالة علمية للانسة نور الهدى عزمي حسن بعنوان"مقاومة المضادات الحيوية وأثرها على نتائج التحاليل المرضية"
تعد المضادات الحيوية من أهم الاكتشافات الطبية التي ساهمت في تقليل معدلات الوفاة الناتجة عن العدوى البكتيرية. ومع ذلك، فإن الاستخدام المفرط أو غير الصحيح لهذه الأدوية أدى إلى ظهور ظاهرة خطيرة تعرف باسم مقاومة المضادات الحيوية.
مقاومة المضادات الحيوية تحدث عندما تتغير البكتيريا بطريقة تجعلها غير حساسة للأدوية التي كانت فعالة في القضاء عليها سابقًا. وهذا الأمر لا يؤثر فقط على العلاج المباشر للمرضى، بل يمتد تأثيره ليشمل نتائج التحاليل المخبرية والتشخيص الدقيق.
أسباب مقاومة المضادات الحيوية
الاستخدام المفرط أو غير الضروري:
تناول المضادات الحيوية عند الإصابة بنزلات البرد الفيروسية.
استخدام المضادات الحيوية بدون وصفة طبية.
العلاج غير المكتمل:
التوقف عن تناول الدواء قبل انتهاء الدورة العلاجية يؤدي إلى بقاء بعض البكتيريا الحية، والتي قد تطور مقاومة.
انتقال البكتيريا المقاومة:
العدوى ببكتيريا مقاومة من بيئة المستشفى أو المجتمع.
التغيرات الجينية للبكتيريا:
التحولات أو الطفرات التي تجعل البكتيريا أقل تأثرًا بالمضاد الحيوي.
أثر مقاومة المضادات الحيوية على نتائج التحاليل المرضية
مقاومة المضادات الحيوية يمكن أن تؤثر بشكل مباشر وغير مباشر على نتائج التحاليل المخبرية بعدة طرق:
التأثير على نمو البكتيريا في المختبر:
عند أخذ عينة من مريض يتناول مضادًا حيويًا، قد لا تنمو البكتيريا في الوسط الغذائي، ما يعطي نتيجة سلبية كاذبة رغم وجود العدوى.
تغير حساسية البكتيريا للأدوية:
الفحص المخبري للحساسية الدوائية قد يظهر مقاومة لمضادات حيوية كانت فعالة سابقًا، مما يغير خطة العلاج.
تأخير التشخيص:
نتيجة التحاليل الخاطئة أو غير الدقيقة، قد يتم تشخيص المرض بشكل خاطئ أو التأخر في تقديم العلاج المناسب.
تأثير على المؤشرات الالتهابية:
استمرار العدوى بسبب مقاومة المضاد الحيوي قد يؤدي إلى ارتفاع مؤشرات الالتهاب مثل CRP أو WBC بشكل مستمر، ما يعطي صورة مضللة عن شدة المرض.
طرق الحد من تأثير مقاومة المضادات الحيوية على التحاليل
جمع العينات قبل بدء العلاج بالمضادات الحيوية.
استخدام طرق مخبرية متقدمة للكشف عن البكتيريا المقاومة.
التأكد من استخدام المضاد الحيوي المناسب حسب نتائج الفحص المخبري.
التثقيف الصحي للمرضى حول أهمية الالتزام بالجرعات الكاملة وعدم استخدام المضادات الحيوية بلا داعٍ.
مقاومة المضادات الحيوية تعد أحد أكبر التحديات التي تواجه الطب الحديث، لأنها تؤثر على التشخيص الدقيق، نتائج التحاليل المخبرية، وفعالية العلاج. ومن الضروري تعزيز الاستخدام الرشيد للأدوية، الاعتماد على التحاليل الدقيقة، وزيادة الوعي الصحي لتجنب تفاقم هذه المشكلة.
جامعة المستقبل الجامعة الاولى في العراق
الهدف الرابع : التعليم الجيد